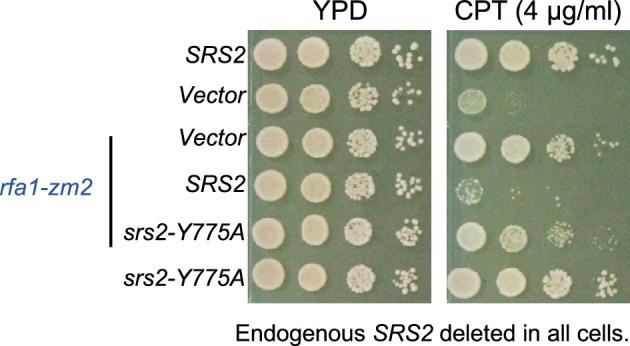
https://cdn.ncbi.nlm.nih.gov/pmc/blobs/9240/12316459/99841469d22c/elife-98843-app1-fig1.jpg

Srs2与增殖细胞核抗原(PCNA)的结合及其SUMO化修饰在DNA损伤反应过程中有助于对抗复制蛋白A(RPA)。
Srs2 binding to proliferating cell nuclear antigen (PCNA) and its sumoylation contribute to replication protein A (RPA) antagonism during the DNA damage response.
作者信息
Fan Jiayi, Dhingra Nalini, Yang Tammy, Yang Vicki, Zhao Xiaolan
机构信息
Molecular Biology Program, Memorial Sloan Kettering Cancer Center, New York, United States.
City University of New York Hunter College, New York, United States.
出版信息
Elife. 2025 Aug 1;13:RP98843. doi: 10.7554/eLife.98843.
Activation of the DNA damage checkpoint upon genotoxin treatment induces a multitude of cellular changes to cope with genome stress. After prolonged genotoxin treatment, the checkpoint can be downregulated to allow cell cycle and growth resumption. In yeast, downregulation of the DNA damage checkpoint requires the Srs2 DNA helicase, which removes the ssDNA binding complex replication protein A (RPA) and the associated Mec1 checkpoint kinase from DNA, thus dampening Mec1-mediated checkpoint. However, it is unclear whether the 'anti-checkpoint' role of Srs2 is temporally and spatially regulated to allow timely checkpoint termination while preventing superfluous RPA removal. Here we address this question by examining regulatory elements of Srs2, such as its phosphorylation, sumoylation, and protein-interaction sites. Our genetic analyses and checkpoint level assessment suggest that the RPA countering role of Srs2 is promoted by Srs2 binding to proliferating cell nuclear antigen (PCNA), which recruits Srs2 to a subset of ssDNA containing regions. RPA antagonism is further fostered by Srs2 sumoylation, which we found depends on the Srs2-PCNA interaction and Mec1, and peaks after Mec1 activity reaches maximal levels. These data support a model in which Srs2 recruitment to PCNA adjacent to ssDNA-RPA filaments, followed by Mec1-dependent sumoylation, modulates RPA-mediated checkpoint signaling, while Srs2 action is limited at ssDNA regions lacking proximal PCNA, thereby favoring RPA-mediated ssDNA protection and repair.
基因毒素处理后DNA损伤检查点的激活会引发众多细胞变化以应对基因组应激。在长时间的基因毒素处理后,检查点可被下调以允许细胞周期和生长恢复。在酵母中,DNA损伤检查点的下调需要Srs2 DNA解旋酶,它从DNA上去除单链DNA结合复合物复制蛋白A(RPA)和相关的Mec1检查点激酶,从而减弱Mec1介导的检查点。然而,尚不清楚Srs2的“抗检查点”作用是否在时间和空间上受到调控,以允许及时终止检查点,同时防止多余的RPA去除。在这里,我们通过检查Srs2的调控元件,如其磷酸化、SUMO化和蛋白质相互作用位点来解决这个问题。我们的遗传分析和检查点水平评估表明,Srs2与增殖细胞核抗原(PCNA)的结合促进了Srs2对RPA的对抗作用,PCNA将Srs2招募到含有单链DNA的区域子集。Srs2的SUMO化进一步促进了对RPA的拮抗作用,我们发现这依赖于Srs2-PCNA相互作用和Mec1,并且在Mec1活性达到最大水平后达到峰值。这些数据支持了一个模型,其中Srs2被招募到与单链DNA-RPA细丝相邻的PCNA上,随后进行Mec1依赖性SUMO化,调节RPA介导的检查点信号传导,而Srs2的作用在缺乏近端PCNA的单链DNA区域受到限制,从而有利于RPA介导的单链DNA保护和修复。